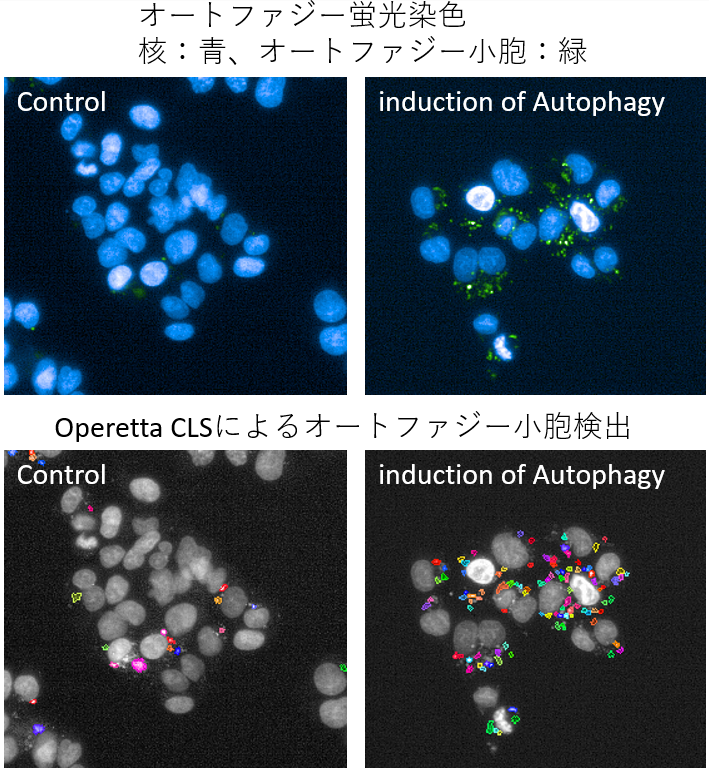

試験概要
オートファジー (自食作用) とは、細胞内において不要になったタンパク質を細胞自身が分解し、新しいタンパク質へ再利用する機構です。それにより細胞内の環境を良い状態に維持することができます。オートファジーは、老化、がん、そしてアルツハイマー病やパーキンソン病といった神経変性疾患の発症に深く関わっていることが報告されております。ノーベル賞を受賞した事もあり、非常に注目を集めています。
本試験では、被験物質のオートファジー促進作用を検証します。
試験例
弊社では細胞ベースでの高速イメージング解析を可能とするハイコンテントスクリーニング機器であるOperetta CLSおよびOpera Phenix Plusを導入しております。生細胞のオートファジー活性状態を高精度かつハイスループットに解析することができます。

基本試験
| 使用細胞 | 肝細胞、神経細胞など各種細胞 |
|---|---|
| 測定項目 | オートファジー蛍光染色、定量 |
参考文献
●長寿とオートファジー
The role of autophagy in aging: its essential part in the anti-aging mechanism of caloric restriction
Bergamini E, Cavallini G, Donati A, Gori Z., Ann N Y Acad Sci. 2007
●加齢によるオートファジーの減弱
Autophagic activity in thymus and liver during aging
Uddin MN, Nishio N, Ito S, Suzuki H, Isobe K., Age. 2012
●がんとオートファジー
Role of autophagy in cancer
Mathew R, Karantza-Wadsworth V, White E., Nat Rev Cancer. 2007
●アルツハイマーとオートファジー
Extensive involvement of autophagy in Alzheimer disease: an immuno-electron microscopy study
Nixon RA, Wegiel J, Kumar A, Yu WH, Peterhoff C, Cataldo A, Cuervo AM., J Neuropathol Exp Neurol. 2005
●パーキンソン病とオートファジー
NDP52 interacts with mitochondrial RNA poly(A) polymerase to promote mitophagy
Furuya N, Kakuta S, Sumiyoshi K, Ando M, Nonaka R, Suzuki A, Kazuno S, Saiki S, Hattori N., EMBO Rep. 2018
※博士号保持者が中心となって試験を担当します。

